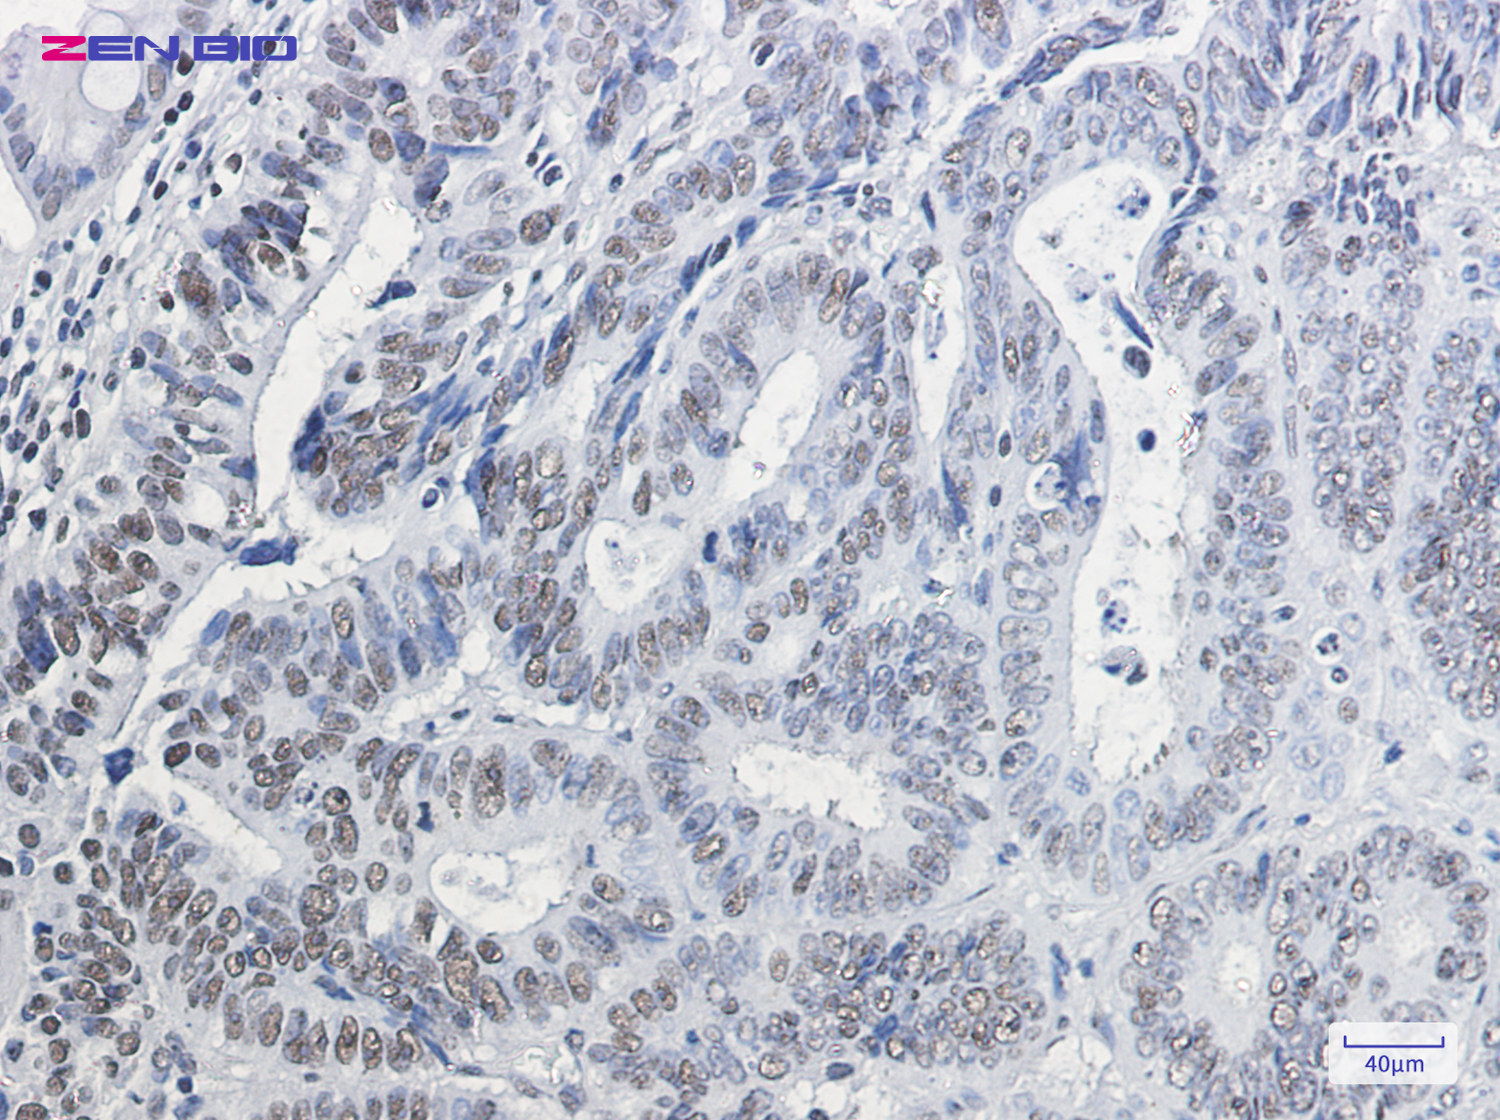
Immunohistochemistry of HP1 gamma in paraffin-embedded Human colon cancer tissue using HP1 gamma Rabbit pAb at dilution 1/20

-
Product Name
Anti-HP1 gamma Rabbit antibody
- Documents
-
Description
HP1 gamma Rabbit polyclonal antibody
-
Tested applications
WB, IHC-P, ICC/IF, FC, IP
-
Species reactivity
Human, Mouse, Rat
-
Alternative names
HECH; HP1-GAMMA; HP1Hs-gamma antibody
-
Isotype
Rabbit IgG
-
Preparation
Antigen: A synthetic peptide of mouse HP1 gamma
-
Clonality
Polyclonal
-
Formulation
Supplied in 50nM Tris-Glycine(pH 7.4), 0.15M Nacl, 40%Glycerol, 0.01% sodium azide and 0.05% BSA.
-
Storage instructions
Store at -20°C. Stable for 12 months from date of receipt.
-
Applications
WB: 1/1000
IHC: 1/20-1/500
ICC/IF: 1/50
FC: 1/50
IP: 1/20
-
Validations

Western blot detection of HP1 gamma in K562,C6,3T3 cell lysates using HP1 gamma Rabbit pAb(1:1000 diluted).Predicted band size:21kDa.Observed band size:21kDa.
Immunohistochemistry of HP1 gamma in paraffin-embedded Human colon cancer tissue using HP1 gamma Rabbit pAb at dilution 1/20
-
Background
Swiss-Prot Acc.P23198.Component of heterochromatin. Recognizes and binds histone H3 tails methylated at 'Lys-9', leading to epigenetic repression. Probably involved in the repression of many genes located in euchromatin, such as E2F1, MYC and CDC25A. Involved in the formation of functional kinetochore through interaction with MIS12 complex proteins. Contributes to the conversion of local chromatin to a heterochromatin-like repressive state through H3 'Lys-9' trimethylation, mediates the recruitment of the methyltransferases SUV39H1 and/or SUV39H2 by the PER complex to the E-box elements of the circadian target genes such as PER2 itself or PER1 (PubMed:24413057). Mediates the recruitement of NIPBL to sites of DNA damage at double-strand breaks (DSBs) .
Related Products / Services
Please note: All products are "FOR RESEARCH USE ONLY AND ARE NOT INTENDED FOR DIAGNOSTIC OR THERAPEUTIC USE"
